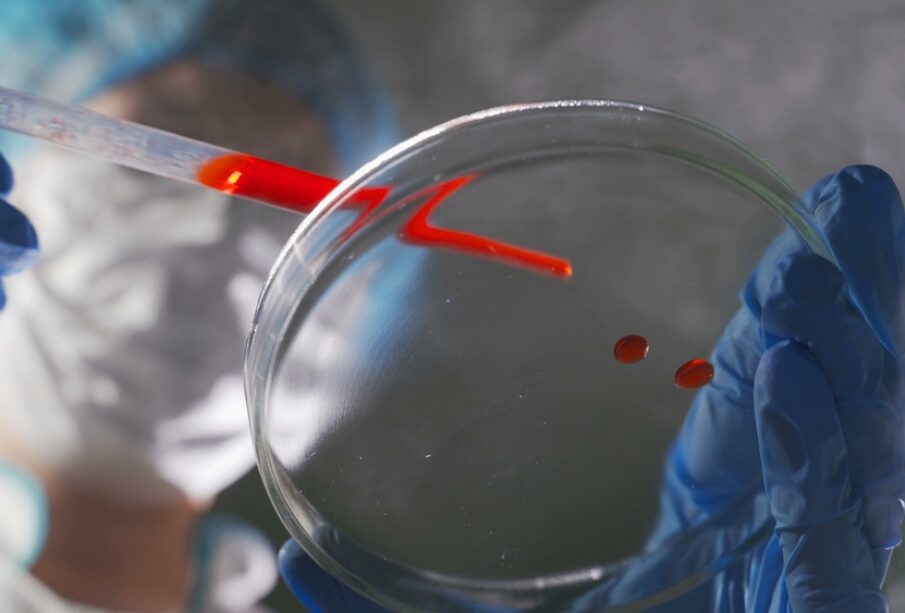

Ιός Epstein-Barr (EBV): Αιτίες, συμπτώματα και θεραπεία
Θα μάθετε
Ο ιός Epstein-Barr (EBV) ανήκει στους πιο συχνούς ιούς που προσβάλλουν τον παγκόσμιο πληθυσμό. Στις περισσότερες περιπτώσεις δεν προκαλεί σοβαρά προβλήματα υγείας, ωστόσο μερικά άτομα μπορεί να εμφανίσουν έντονα ή ακόμη και επικίνδυνα συμπτώματα. Ο EBV συνδέεται κυρίως με τη λοιμώδη μονοπυρήνωση, όμως μπορεί να σχετίζεται και με διάφορες άλλες παθήσεις.
Διάγνωση της λοίμωξης
Τα συμπτώματα όπως ο πυρετός, η κόπωση ή ο πονόλαιμος δεν είναι αποκλειστικά στην εν λόγω λοίμωξη και συναντώνται σε κοινό κρυολόγημα ή άλλες ιώσεις. Μόνο η κλινική εκτίμηση και οι κατάλληλες εξετάσεις μπορούν να αναδείξουν τον ακριβή λόγο της αδιαθεσίας. Κατά την ιατρική εξέταση, συχνά παρατηρείται διόγκωση του σπλήνα, ενίοτε πρήξιμο των ιστών, δημιουργία μεμβρανών στις αμυγδαλές ή διόγκωση του ήπατος.
Εργαστηριακές εξετάσεις για ebv
Ο γιατρός μπορεί να προτείνει αιματολογικές εξετάσεις για να επιβεβαιωθεί η παρουσία του EBV. Κάποιες εξετάσεις ανιχνεύουν εξειδικευμένα αντισώματα στον οργανισμό, δείχνοντας αν υπάρχει ενεργή ή παλαιότερη μόλυνση. Επίσης εξετάζεται συνήθως αν υπάρχει αύξηση συγκεκριμένων λευκοκυττάρων που συνδέονται με την αντίδραση στην ίωση.
Υπάρχουν επίσης ταχείες διαγνωστικές δοκιμές που διατίθενται στο εμπόριο, αλλά η ακρίβειά τους υπολείπεται των εργαστηριακών μεθόδων. Συχνά τα συγκεκριμένα τεστ οδηγούν σε ανακριβή αποτελέσματα, για αυτό δεν συνιστώνται ως κύρια διαγνωστική προσέγγιση.
Δυνατότητες θεραπείας
Αντιβιοτικά δεν έχουν αποτελεσματικότητα έναντι του EBV και χορηγούνται μόνο σε περίπτωση επιπρόσθετης βακτηριακής λοίμωξης. Εξειδικευμένα φάρμακα που στοχεύουν απευθείας τον EBV δεν υπάρχουν ακόμη στη θεραπεία, αν και εξετάζονται πειραματικά δραστικές ουσίες όπως η διπυριδαμόλη η οποία χρησιμοποιείται για πρόληψη θρομβώσεων, αλλά διερευνάται αν μπορεί να μειώσει τη δραστικότητα του ιού.
Τα συμπτώματα συνήθως υποχωρούν εντός μερικών εβδομάδων. Συνιστάται ξεκούραση στο σπίτι, ενυδάτωση με επαρκή λήψη υγρών και χρήση μη συνταγογραφούμενων σκευασμάτων για την αντιμετώπιση του πυρετού ή του πόνου. Είναι καλό να αποφεύγεται η έντονη σωματική δραστηριότητα μέχρι η διόγκωση του σπλήνα να υποχωρήσει πλήρως.
Πιθανές επιπλοκές
- Περιστασιακά ο ιός προσβάλλει το μυοκάρδιο και προκαλεί μυοκαρδίτιδα.
- Σε ορισμένα άτομα αυξάνεται ο κίνδυνος για ανάπτυξη κακοήθειας, όπως λεμφώματα τύπου Burkitt, Hodgkin ή μη Hodgkin ή καρκίνους του φάρυγγα.
- Οι αναπνευστικές παθήσεις, όπως η πνευμονία, συγκαταλέγονται στις πιθανές επιπλοκές.
- Νευρολογικές επιπτώσεις, όπως μηνιγγίτιδα, εγκεφαλίτιδα ή το σύνδρομο Guillain-Barré, μπορεί επίσης να παρατηρηθούν.
- Σε σοβαρές περιπτώσεις υπάρχει κίνδυνος ρήξης σπλήνα.
- Φλεγμονές όπως ιγμορίτιδα, διόγκωση αμυγδαλών ή παγκρέατος δύναται να εμφανιστούν.
- Ενδέχεται να αποδυναμωθεί το ανοσοποιητικό σύστημα, οδηγώντας σε μεγαλύτερη ευαισθησία σε λοιμώξεις.
Επίμονα ή επανεμφανιζόμενα συμπτώματα
Μετά την οξεία φάση, ο EBV συνήθως παραμένει αδρανής στον οργανισμό, σε κάποιες περιπτώσεις όμως τα συμπτώματα παραμένουν για πολλούς μήνες, κάτι που μπορεί να υποδηλώνει χρόνια ενεργή λοίμωξη από EBV. Συχνά εκδηλώνεται επίμονος πυρετός, διόγκωση λεμφαδένων, αύξηση του μεγέθους ήπατος ή σπλήνα.
Ο ιός μπορεί σε ορισμένες περιπτώσεις να επανενεργοποιηθεί μετά από μεγάλο χρονικό διάστημα, ιδιαίτερα όταν το ανοσοποιητικό σύστημα είναι αποδυναμωμένο. Σε αυτές τις περιπτώσεις, τα συμπτώματα όπως ο πυρετός, ο πονόλαιμος, η διόγκωση λεμφαδένων στον τράχηλο, η αύξηση μεγέθους των εσωτερικών οργάνων και η κόπωση μπορεί να επανεμφανιστούν.
Ανακούφιση των συμπτωμάτων στο σπίτι
- Ξεκούραση μέχρι να υποχωρήσουν τα έντονα συμπτώματα.
- Κατανάλωση άφθονου νερού και άλλων υγρών.
- Για την ανακούφιση του πονόλαιμου βοηθούν το ζεστό αλατόνερο, παγάκια ή παγωτά.
- Σε περίπτωση πυρετού ή πόνου, χορηγείται παρακεταμόλη ή ιβουπροφαίνη (η ασπιρίνη δεν ενδείκνυται σε παιδιά).
- Η επιστροφή στη δουλειά ή στο σχολείο πρέπει να γίνεται σταδιακά ενώ η αποφυγή αθλητικών δραστηριοτήτων ή άρσης βαρών είναι απαραίτητη για τουλάχιστον ένα μήνα ώστε να προστατευθεί ο σπλήνας από τραυματισμό.
Διατροφή και λοίμωξη ebv
Δεν υπάρχουν διατροφικές οδηγίες που να θεραπεύουν απευθείας τον EBV, ωστόσο η ισορροπημένη διατροφή πλούσια σε αντιοξειδωτικά ενισχύει το ανοσοποιητικό. Συνίσταται αφθονία σε ωμά λαχανικά και φρούτα του δάσους, παράλληλα με επαρκή ενυδάτωση. Η κατανάλωση καφεΐνης πρέπει να γίνεται με μέτρο διότι χωρίς αυτή επιτυγχάνεται καλύτερη ενυδάτωση, ενώ η υπερβολική καφεΐνη μπορεί να αυξήσει τον κίνδυνο ορισμένων τύπων καρκίνου.
Εμβόλια για τον ιό epstein-barr
Αυτή τη στιγμή δεν υπάρχει διαθέσιμο εμβόλιο για τον EBV, ωστόσο βρίσκονται σε εξέλιξη έρευνες και κλινικές δοκιμές με στόχο την ανάπτυξή του στο μέλλον. Μέχρι να κυκλοφορήσουν εμβόλια, ο καλύτερος τρόπος πρόληψης είναι να αποφεύγεται η στενή επαφή με άτομα που φέρουν τη λοίμωξη, ειδικά εάν έχει διαγνωστεί λοιμώδης μονοπυρήνωση.
- Να αποφεύγεται η ανταλλαγή φιλιών με άτομα που έχουν προσβληθεί από τον ιό.
- Μη χρησιμοποιείτε κοινά σκεύη ή ποτά με άλλα άτομα.
- Προσωπικά είδη όπως ποτήρια ή οδοντόβουρτσες να είναι ατομικά.
- Σεξουαλική επαφή να γίνεται με τη χρήση προστατευτικών μέσων.
- Τακτικό πλύσιμο χεριών, ειδικά μετά από επαφή με αντικείμενα που πιθανώς ήρθαν σε επαφή με σάλιο μολυσμένου ατόμου.
Πότε να επικοινωνήσετε με γιατρό
- Εάν παρουσιαστεί έντονος ή οξύς πόνος στην αριστερή πλευρά της κοιλιάς, γεγονός που μπορεί να υποδηλώνει πρόβλημα στον σπλήνα.
- Σε πολύ μικρή παραγωγή ούρων, δείγμα αφυδάτωσης.
- Σε δυσκολία αναπνοής ή κατάποσης, είναι απαραίτητη η άμεση ιατρική συμβουλή.
- Αν τα συμπτώματα δεν υποχωρήσουν εντός 4–6 εβδομάδων, συστήνεται επικοινωνία με γιατρό καθώς αυτό ενδέχεται να σχετίζεται με άλλη λοίμωξη.
Άλλες παθήσεις που σχετίζονται με τον ebv
- Στα παιδιά προσβάλλεται συχνά το αυτί και εκδηλώνεται διάρροια.
- Είναι πιθανή η εμφάνιση του συνδρόμου Guillain-Barré.
- Ορισμένα είδη καρκίνου, όπως λεμφώματα τύπου Burkitt και όγκοι του ρινοφάρυγγα, σχετίζονται με τον ιό.
- Σπάνια, μετά από μεταμόσχευση οργάνων ή αιμοποιητικών κυττάρων, εκδηλώνονται λεμφοϋπερπλαστικές διαταραχές.
Σύνδεση του ebv με τη σκλήρυνση κατά πλάκας
Έχει διαπιστωθεί ότι τα άτομα που έχουν προσβληθεί από EBV εμφανίζουν σημαντικά υψηλότερο κίνδυνο να αναπτύξουν σκλήρυνση κατά πλάκας συγκριτικά με εκείνους που δεν έχουν εκτεθεί στον ιό. Παρόλα αυτά, ακόμα και αν ο EBV έχει μολύνει σχεδόν όλους τους ενήλικες, η συγκεκριμένη νόσος εμφανίζεται μόνο σε μικρό μέρος του πληθυσμού.
Σημεία κλειδιά
Ο ιός Epstein-Barr είναι ιδιαίτερα μεταδοτικός και μεταφέρεται μέσω σωματικών υγρών, κυρίως σάλιου. Τα πλέον συνήθη συμπτώματα είναι ο πονόλαιμος, ο υψηλός πυρετός και η έντονη κόπωση. Από τη στιγμή που ο ιός εισέλθει στον οργανισμό παραμένει διά βίου, μπορεί να προκαλέσει προσωρινές ενοχλήσεις ή να παραμένει αδρανής για μεγάλο χρονικό διάστημα.










